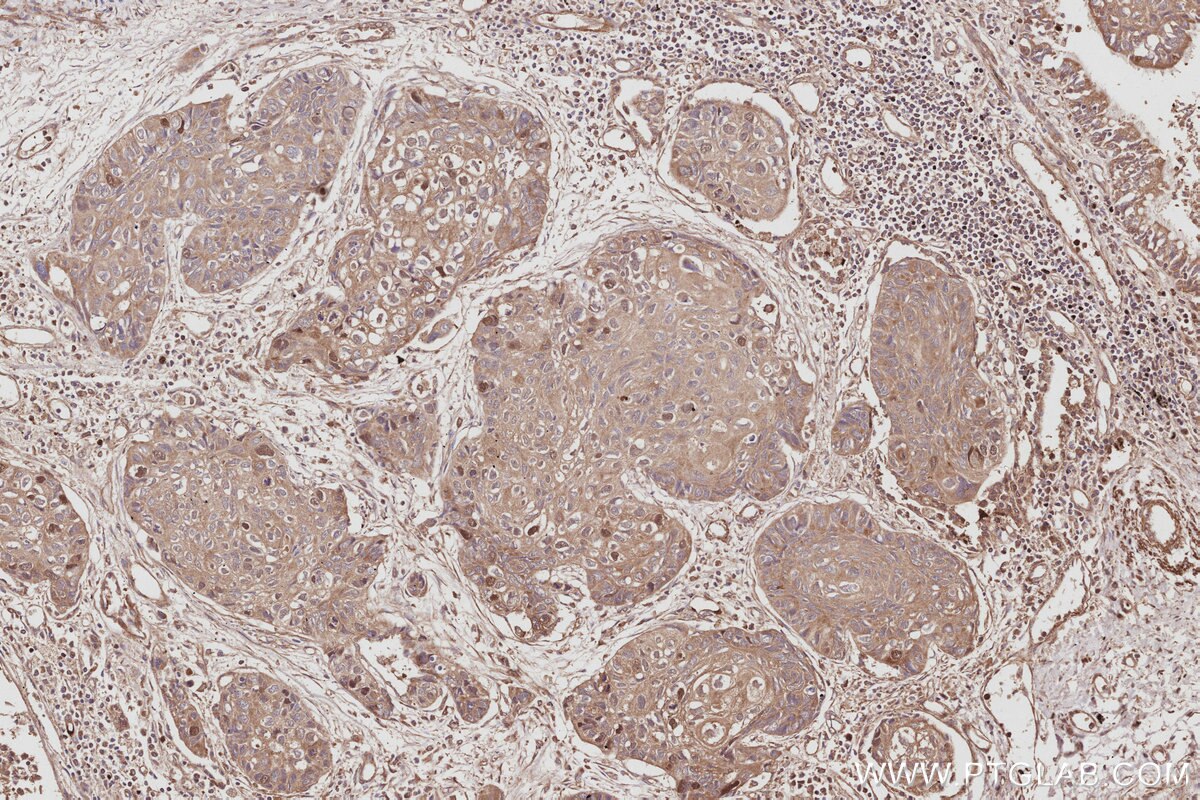

IHCeasy® ECT2 Ready-To-Use IHC Kit
ECT2 Ready-to-use reagent kit for IHC.
Reactivity
Human, Mouse
Sample Type
FFPE tissue
Cat no : KHC2964
Synonyms
Epithelial cell-transforming sequence 2 oncogene, Protein ECT2
Validation Data Gallery
Product Information
KHC2964 is a ready-to-use IHC kit for staining of ECT2. The kit provides all reagents, from antigen retrieval to cover slip mounting, that require little to no diluting or handling prior to use. Simply apply the reagents to your sample slide according to the protocol and you're steps away from obtaining high-quality IHC data.
| Product name | IHCeasy® ECT2 Ready-To-Use IHC Kit |
| Sample type | FFPE tissue |
| Assay type | Immunohistochemistry |
| Primary antibody type | Rabbit Polyclonal |
| Secondary antibody type | Polymer-HRP-Goat anti-Rabbit |
| Reactivity | Human, Mouse |
Kit components
| Component | Size | Concentration |
|---|---|---|
| Antigen Retrieval Buffer | 100 mL | 50× |
| Washing Buffer | 100 mL ×2 | 20× |
| Blocking Buffer | 5 mL | RTU |
| Primary Antibody | 5 mL | RTU |
| Secondary Antibody | 5 mL | RTU |
| Chromogen Component A | 0.2 mL | RTU |
| Chromogen Component B | 4 mL | RTU |
| Signal Enhancer | 5 mL | RTU |
| Counter Staining Reagent | 5 mL | RTU |
| Mounting Media | 5 mL | RTU |
| Datasheet | 1 Copy | |
| Manual | 1 Copy |
Background Information
Epithelial cell transforming sequence 2 (Ect2) is a guanine nucleotide exchange factor (GEF) for the Rho family GTPases, Rac1, RhoA and Cdc42. Ect2 catalyzes the exchange of GDP for GTP, thereby activating the Rho GTPases toward their downstream effectors. The cellular localization of Ect2 is cell cycle dependent. Ect2 is localized predominantly in the nucleus during interphase due to two functional NLS sequences found within its central hinge region.1 At the onset of mitosis, Ect2 is dispersed throughout the cytoplasm where it associates with the mitotic spindle at metaphase, the cleavage furrow during telophase, and the mid-body during cytokinesis. Besides normal cellular activity, ECT2 also participates in malignant transformation, tumor initiation, and metastasis.
Properties
| Storage Instructions | All the reagents are stored at 2-8°C. The kit is stable for 6 months from the date of receipt. |
| Synonyms | Epithelial cell-transforming sequence 2 oncogene, Protein ECT2 |